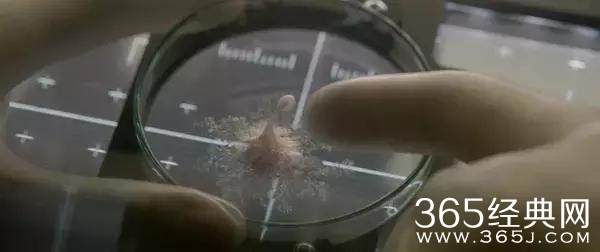

无论本片有多少值得大家大吐特吐的槽点,但是依然不妨碍小菱对此片加以赞美,导演城会玩儿,从《太空漫游2001》到《异形》系列,再到《地心引力》,很多拿来主义,造就了自己极富个人风格的作品,节奏快,情节通俗凌厉,流畅长镜头,反大团圆结尾——青出于蓝胜于蓝,杜比影院加持后,观影体验极佳。

的确,这并不是极具新意的故事,地球人外太空大战外星智慧生物我们已经见怪不怪,所以本片好看在哪里了呢?

一、恐怖不血腥
相比与《异形》而言,本片中会令人产生生理不适感的“开肠破肚”画面少之又少,恐怖感主要来自于音乐烘托,以及通过人物行为反映出的孤立无援感。我们会担忧两件事,一个是火星天团成员的存活问题,还有一个就是关乎全世界80亿人是否存在安全隐患的问题。对后者的担忧,此类影片很少提及,但是想想的确是个巨大的问题,万一穿过大气层掉进地球,就又要惊动复联啊正义联盟那一众人马在地球上掀起一阵血雨腥风!想想就很累,观影时甚至害怕凯尔文那软趴趴的触手在船舱匍匐前行时一个不小心滑下来掉进地球里,如此一来,事态就会从智斗一个单纯想活命所以必须杀掉所有可见潜在威胁外星的生物,变成地球各国之间政治斡旋的玩儿心战。

二、情感线令人动容
怎么讲,尽管他们很爱zuo死,比如从外面捡了一活物没闹明白就感带回船舱实验室里养,还美b美当成是个重大发现开开心心聚餐有说有笑。尽管他们像愣头青,解决问题永远慢半拍,也不乏科学工作者长篇大论批判这部电影中从科学家到飞船硬件配置的不科学性,连最基本的实验室安全协议都无法做到严格遵守,但不得不说他们的思想觉悟实在都太高了,几乎每个人都想在危难之中不顾自己安危挽救他人生命于万一。这种团结友爱的精神非常让人感动!在生存战的缝隙中透露人性中感性一面,虽然在这个场景中确实违和,但普通观众看来无碍,甚至会相信,人在太空的极端环境中,感性战胜理性,也是再正常不过的事情。

三、神结尾助攻神作
最后只有一个人能活!救赎成功的欢喜结局大概是近年来太空类型片的共性,本片不例外,赋予一人生还机会。观影前看无剧透评论,说本片有着出人意表的结尾,便让人想入非非。到底是怎样的结局。小菱脑洞大开,以为结尾会把杰克·吉伦哈尔全程黑化阴谋论揭开,然而事实并不是这样。之所以有这种想法,是因为全片几次强调杰克G的厌世情结啊,对地球上的80亿人完全无爱,有一定的动机给全人类带去灾难啊。不过本片导演对于结尾解释了一下,原文:“On the other hand, there is this idea that Calvin finally managed to communicate. Therefore, he never killed Gyllenhaal. He never saw him as a threat. He is the person that had some connection with this creature.”凯文并没有视杰克G为他的威胁,只是将他作为一个试图去沟通的对象。

四、私心~每个演员都深得我心啊
整体颜值太高,颜狗全程心眼,演技在线,即便蠢萌,也能时刻靠颜艺拉动紧迫感,总之,太 养 眼!

红菱评分:★★★★ 推荐
观影年龄建议:18岁以上
适宜观影氛围和人群:颜狗~520/521约会团~恐怖片迷~怪兽迷
陪同父母观看适宜程度:★★ 不太适宜
本文所用图片均来源于网络

娱乐圈中被包养的女星数不胜数,包养男人的女星也数不胜数,但是很多女星被包养后还死 ...
讲到女性做爱至高潮算得上是一件很神秘的事情,因为男女之间的区别,男性在高潮时伴有 ...
近日,一美国19岁女孩在图书馆里面不管不顾公众场所,公然自慰事件引起了网友们的关注 ...
昨天,院长写了一篇关于电影《大只佬》的原版解析。这部当年囊括23届金像奖多个奖项的 ...
据韩国媒体日刊体育报道,《RunningMan》改版,金钟国被裁,宋智孝也被节目组抛弃。宋 ...